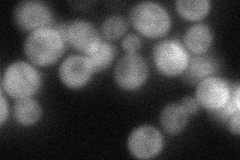
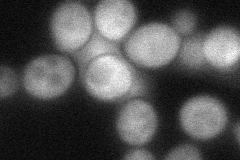
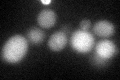

View description
Glutathione synthetase, catalyzes the ATP-dependent synthesis of glutathione (GSH) from gamma-glutamylcysteine and glycine; induced by oxidative stress and heat shock
Localization:
Intensity:
Fold change:
Significance:
-
C’ GFP library in SD

below threshold19.4 -
N' NOP1pr-GFP in SD

cytosol191.099 -
N' TEF2pr-mCherry in SD

cytosol233.967 -
N' NATIVEpr-GFP in SD
cytosol51.3779 -
N' TEF2pr-VC and Cyto-VN in SD
cytosol69.0812 -
C’ GFP library in SD+DTT
cytosol21.981.13No -
C’ GFP library in SD+H2O2

cytosol20.861.07No -
C’ GFP library in Starvation Media

cytosol17.780.91No -
C’ GFP library on the background of Pup2-DaMP

below threshold -
C’ GFP library on the background of CCT mutant

below threshold26.93891.38783No
